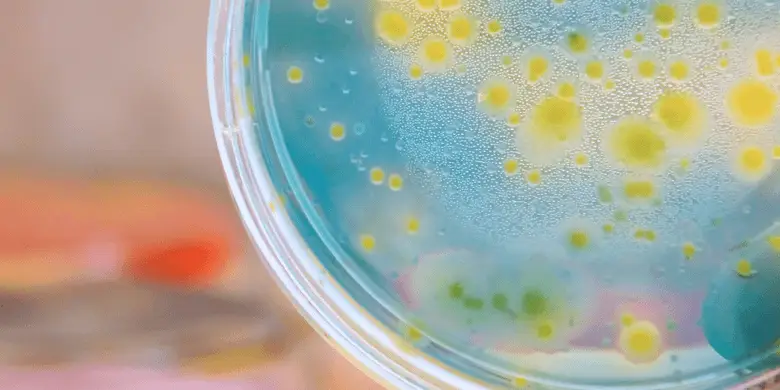

Teñido microbiano: colores biológicos para un futuro textil sostenible
La industria textil es una de las más contaminantes del mundo, especialmente en lo que respecta al...
La industria textil es una de las más contaminantes del mundo, especialmente en lo que respecta al uso de tintes. Los procesos de tintura tradicionales consumen grandes volúmenes de agua y productos químicos tóxicos, generando una enorme carga de contaminación en ríos y ecosistemas. Se calcula que hasta el 20% de la contaminación industrial del agua a nivel global proviene de la tintura y el tratamiento de textiles.
Ante este desafío, ha surgido una alternativa innovadora: la tintura microbiana. Gracias a los avances en biotecnología, los científicos están desarrollando microorganismos capaces de producir pigmentos naturales y teñir tejidos mediante procesos biológicos. Esta técnica no solo reduce la contaminación del agua, sino también el consumo de energía y la huella de carbono.
El problema de los tintes tradicionales
El teñido convencional de textiles es uno de los procesos más contaminantes de toda la industria de la moda. Se estima que cada año se utilizan más de 5 billones de litros de agua solo para teñir tejido, y gran parte de esta agua acaba contaminada con colorantes sintéticos, metales pesados y productos químicos tóxicos.
Además, según datos del World Resources Institute, el teñido y acabado de textiles genera hasta 20% de la contaminación industrial del agua a nivel mundial.
Muchos de estos colorantes no son biodegradables y permanecen en los ecosistemas acuáticos, afectando la biodiversidad y la salud humana.
El impacto no es solo hídrico. El proceso de teñido requiere temperaturas elevadas, múltiples enjuagues y tratamientos químicos intensivos, lo que implica un consumo energético alto y emisiones de CO₂ significativas. Además, los residuos generados a menudo no se gestionan de manera segura, especialmente en países sin una regulación ambiental estricta.
¿Cómo funciona el teñido microbiano?
El teñido microbiano utiliza organismos vivos, como bacterias, levaduras u hongos modificados genéticamente, que producen pigmentos naturales durante procesos de fermentación. Estos microorganismos se cultivan en condiciones controladas y alimentados con fuentes de carbono como azúcar o residuos orgánicos, generando colores como el índigo, el violeta, el rosa o el amarillo de forma natural.
Uno de los mecanismos más comunes es la inserción de genes responsables de la producción de pigmentos (como la indigotina o los carotenoides) en microbios seguros, como la Escherichia coli o algunas cepas de Saccharomyces cerevisiae. Estos microbios, una vez optimizados, pueden fabricar grandes cantidades de pigmentos en biorreactores, en procesos similares a los de la producción de cerveza o antibióticos..
Una vez producido el pigmento, el colorante se extrae o se aplica directamente sobre el tejido durante el proceso de fermentación, lo que permite un teñido más uniforme, con menos agua, menor temperatura y sin necesidad de productos químicos tóxicos. Además, al tratarse de un sistema cerrado, es más fácil reciclar el agua y controlar los residuos.
Este enfoque representa un cambio radical frente a los métodos tradicionales, eliminando muchos de los pasos contaminantes del teñido industrial.
Beneficios medioambientales
Uno de los mayores beneficios del teñido microbiano es su capacidad para reducir drásticamente el uso de agua y evitar la liberación de contaminantes en el entorno. A diferencia de los tintes sintéticos tradicionales, que requieren grandes cantidades de agua para fijar el color y enjuagar los productos químicos residuales, el teñido microbiano puede realizarse en sistemas cerrados, donde el agua se recicla y los vertidos se minimizan.
El proceso también elimina el uso de mordientes metálicos y colorantes no biodegradables que suelen acabar en ríos y suelos, dañando la biodiversidad. El Banco Mundial estima que, como hemos visto antes, la industria textil genera aproximadamente el 20 % de la contaminación industrial del agua a nivel mundial. El teñido microbiano, al utilizar procesos biológicos suaves y sin compuestos tóxicos, ofrece una alternativa segura y regenerativa.
Además, al operar a temperaturas más bajas y con menos etapas de procesamiento, este método reduce el consumo energético. Según varios estudios de ciclo de vida (LCA), esta tecnología puede suponer una reducción significativa de la huella de carbono asociada a la fase de teñido, especialmente si se alimenta con fuentes renovables y residuos orgánicos.
Retos y potencial de futuro
Aunque el teñido microbiano ofrece un enfoque prometedor, todavía enfrenta desafíos importantes en su aplicación a gran escala. Uno de los principales obstáculos es la escalabilidad: producir suficientes pigmentos biológicos para satisfacer las necesidades industriales requiere instalaciones especializadas, biorreactores eficientes y un control riguroso del proceso.
Además, la gama cromática disponible con microorganismos sigue siendo limitada en comparación con los tintes sintéticos tradicionales. Aunque ya se han logrado colores intensos como el índigo y diversos tonos tierra, el desarrollo de una paleta completa aún requiere más investigación en biología sintética y selección de cepas.
La adopción por parte de la industria textil también avanza lentamente, en parte por el desconocimiento técnico, las posibles modificaciones necesarias en los procesos existentes y el coste inicial de la inversión en nuevas tecnologías.
Sin embargo, el potencial es enorme. Con más inversión en I+D, se espera que los científicos puedan modificar genéticamente microbios para ampliar su producción de pigmentos y hacer el proceso más rápido, más versátil y aún más eficiente. También hay oportunidades para combinaciones híbridas, donde el teñido microbiano se integre con otras innovaciones sostenibles como fibras biodegradables o acabados libres de PFAS.
A medida que aumente la presión regulatoria y la demanda del consumidor por soluciones respetuosas con el medio ambiente, es probable que estas tecnologías evolucionen desde la fase piloto hacia la producción industrial, transformando la forma en que coloreamos nuestras prendas.
Conclusión
El teñido microbiano representa una convergencia transformadora entre la química, la biotecnología y la sostenibilidad. Al reemplazar los tintes sintéticos tradicionales por pigmentos producidos de forma biológica, esta tecnología ofrece una alternativa más limpia, eficiente y respetuosa con el medio ambiente.
En un contexto donde la industria textil es responsable de una parte significativa de la contaminación del agua y del consumo de recursos, estas soluciones bio-basadas marcan el camino hacia un futuro más circular y responsable. Además, al aprovechar procesos de fermentación naturales, se reducen tanto el uso de energía como las emisiones de carbono, contribuyendo a mitigar el impacto ambiental de la moda.
Este tipo de innovación demuestra cómo la química aplicada puede ser parte de la solución, no solo del problema. Desde ADRASA, seguimos con atención los avances que transforman la industria, con el convencimiento de que la sostenibilidad y la ciencia deben ir de la mano para construir una nueva generación de textiles.
¿Trabajas con tintes o acabados textiles? ¿Estás explorando procesos más responsables? Escríbenos y compartimos ideas.
Contacta con el equipo de ADRASA:
https://www.adrasa.name/contacto-confecci%C3%B3n




